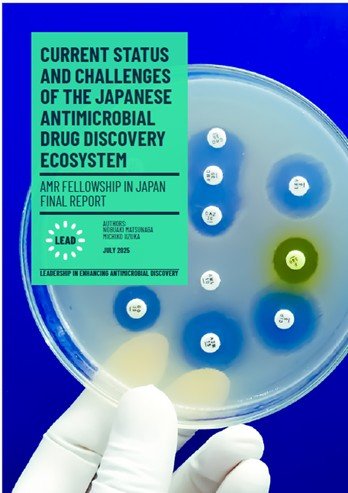
AMRreport_cover.jpg

The National Graduate Institute for Policy Studies (GRIPS) and the Institute of Development Studies (IDS), the United Kingdom have been jointly implementing an Antimicrobial Resistance (AMR) Fellowship Program since last fiscal year, with support from the Great Britain Sasakawa Foundation. This program, named after Professor Dame Sally Davies and Mr. Yasuhisa Shiozaki, is part of a Japan-UK partnership initiative (valued at £1.5 million) led by Professor Chris Dowson of the University of Warwick.
As part of this program, Mr. Shiozaki (former Minister of Health, Labour and Welfare) delivered a lecture on AMR at the GRIPS Forum on December 16 2024, followed by a panel discussion with the two fellows selected for the first cohort: Dr. Alicia Demirjian (UK Health Security Agency: UKHSA) and Dr. Nobuaki Matsunaga (NCGM / currently Japan Institute for Health Security: JIHS).
Through their training and research conducted in both Japan and the UK, the fellows have produced their respective outputs. A report titled "CURRENT STATUS AND CHALLENGES OF THE JAPANESE ANTIMICROBIAL DRUG DISCOVERY ECOSYSTEM" was recently published on the LEAD website. The report outlines the background of AMR, the necessity of an antimicrobial ecosystem, an analysis of the current situation regarding AMR and antimicrobial development in Japan, and related policy recommendations.
The report was authored by Dr. Nobuaki Matsunaga, Head of Clinical Epidemiology, AMR Clinical Reference Center (1st Cohort AMR fellow) and Professor Michiko Iizuka of GRIPS, with significant contributions from Dr. Yasunori Tawaragi, Representative of Yasubio Pharma Consulting, and Dr. Norio Ohmagari, Director of the NCGM AMR Clinical Reference Center. The report is available in Japanese and English.
LEAD website can be found at the following link: